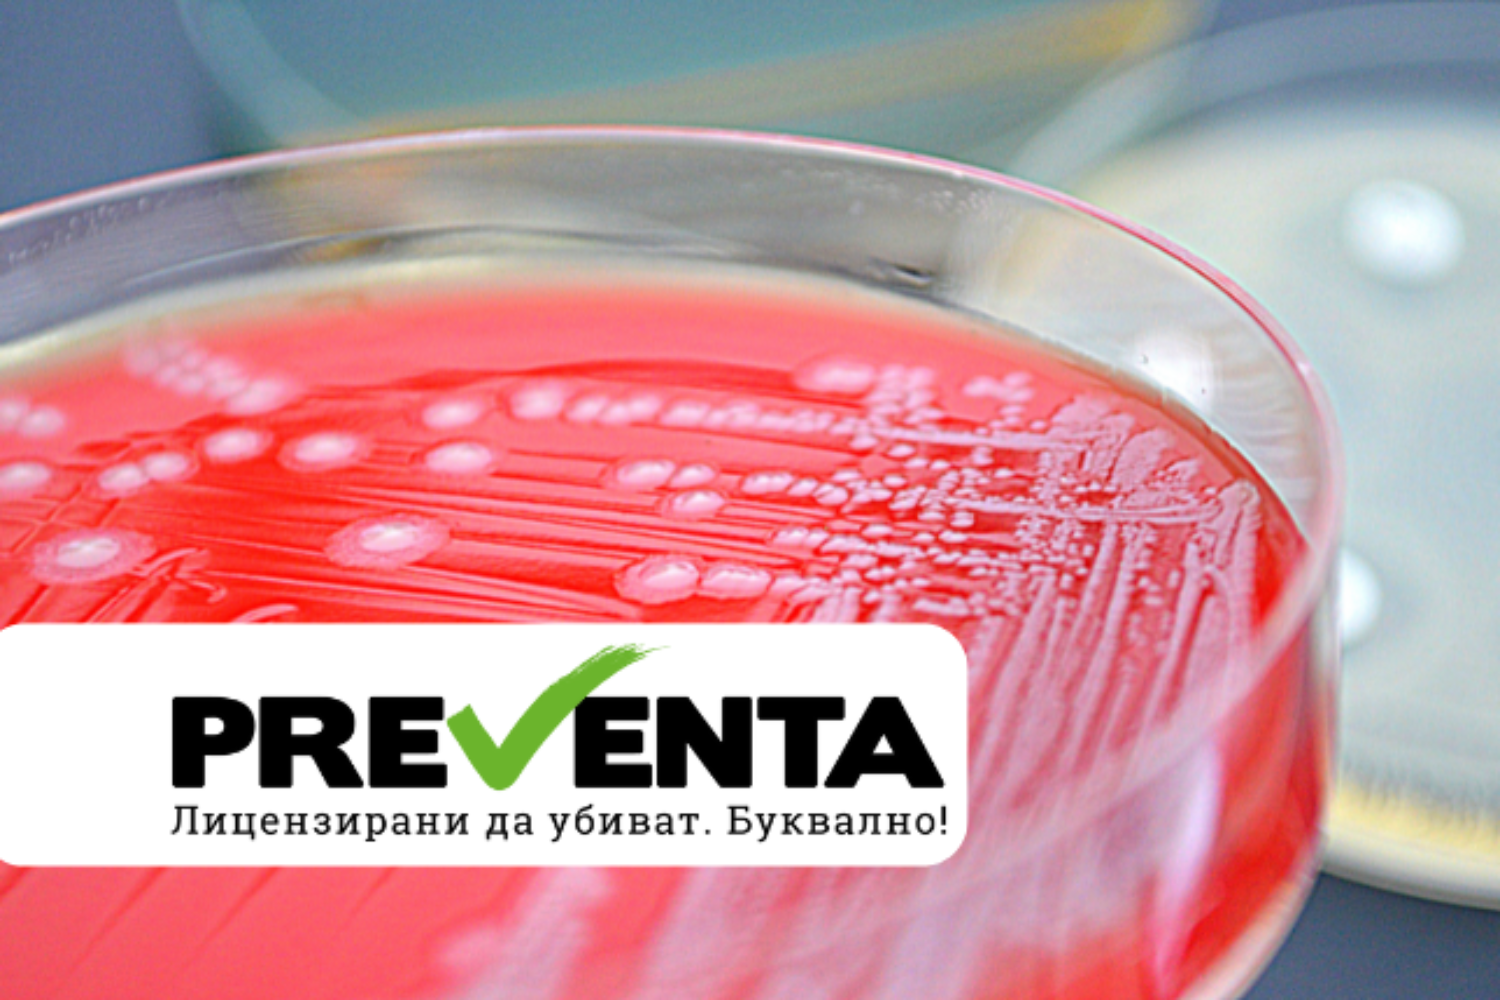

Забелязали ли сте, че червеният цвят на някои храни и козметични продукти е изненадващо естествен? Може би, защото се дължи на оцветител, добит от насекоми. Да, правилно прочетохте! Зад популярния оцветител Е120, известен още като кармин, стои кохинилът – едно малко и необичайно насекомо.
Как точно тези насекоми се превръщат в багрило, което намираме в червила и сладкиши? И доколко то е безопасно? Отговори на тези въпроси, както и интересни факти за оцветителя, добиван от насекоми, ще намерите в следващите редове.
Съдържание
Оцветителите и тяхната роля в индустрията
Оцветителите в хранителната индустрия са наболяла тема. От какво са произведени и какъв е техният състав? Вредни ли са? Всички оцветители ли са вредни?
Около това се въртят въпросите и дискусиите по темата. И съвсем естествено да е така, при положение, че това е част от храната, кото консумираме ние и нашите деца. Оцветителите могат да бъдат изкуствено синтезирани, плод на химическата индустрия или да бъдат продукт от различни природни вещества. В случая става дума за натурален оцветител.
Кохинил: насекомото, от което се извлича червеното багрило Е120
Насекомото, от което се извлича това багрило, се нарича кохинил или Dactylopius coccus. Местообитанието му традиционно е Централна и Южна Америка. Най-често това насекомо се среща в Мексико и Аризона. Представителите на вида живеят на определен вид кактуси от вида Опунтия. Кохинилите се хранят с хранителните вещества и сокове на кактуси. Това е класическа форма на паразитизъм.
Насекомите кохинили и по-специално женските са с дължина 5мм. и паразитират върху кактуси. След снасянето на яйцата и излюпването им, малките бъдещи кохинили също се закрепват към кактусите чрез прозрачна слузеста течност.
Тялото на насекомите произвежда пигмент, благодарение на който те изглеждат тъмно лилави. Всъщност това е и пигментът, който се извлича, за да се вложи в последствие в хранителни вещества и козметични продукти. На външен вид женските от мъжките кохинили се различават лесно. Мъжките са видимо по-малки и имат крила. На женските крила не са им нужни, тъй като те живеят спокойно залепени върху кактусите.
Процес на извличане на оцветителя кармин
Кохинилите произвеждат карминова киселина, чието предназначение е да ги защитава от останалите насекоми. Карминовата киселина представлява между 17 и 24% от масата на мъртвите „изсушени“ насекоми. Тя може да бъде извлечена от тялото или от яйцата на кохинилите. След извличането ѝ тя се смесва с алуминиеви или калциеви соли и по този начин се получава карминова боя, позната и под наименованието кохинил или пък Е120. Да, точно така, говорим за поредното от „Е-тата“.
За целите на извличането на веществото кармин, женските кохинили биват отглеждани в специални условия, нещо като промишлено отглеждане. На големи насаждения от кактуси се развъждат кохинили. Пълният цикъл на „настаняване“ на кохинилите, отглеждането им, снасянето на яйцата отнема три месеца. През това време кактусите биват държани на постоянна температура от 27˚. След тези три месеца част от популацията бива оставена да продължи размножаването си, а останалата част се събира, за да се извлече веществото кармин.
За по-голямо удобство, вместо да се събират самите насекоми и техните яйца, при изкуствено отглежданите „плантации“ от кактуси се събират листата на самите растения. Докато се извлече сухото вещество, листата биват съхраняване в парници или оранжерии. С тази добре разработена процедура се улеснява процесът на събиране на кармин.
Работниците, които участват в процеса на събиране на кармина, използват фини четки, за да отстранят кохинилите от кактусите. След това изтискват насекомите, за да извлекат от тях червеното багрило, произвеждано от техните тела.
За производството на един паунд или 453,5гр. сухо вещество кармин са необходими около 70 000 насекоми. Това багрило се използва от много векове. Употребата му датира от 15в., когато населението на Централна и Южна Америка започнало да използва насекомите, за да добива от тях червения цвят. Днес най-големият износител на червеното багрило, добивано от кохинили, е Перу. Страната произвежда близо 200 тона кармин годишно.
Въпросното Е120 се използва като багрило за храни и в козметиката. Особено подходящо е за червени червила, тъй като не се налага смесването му с други цветове.
Всеки път, когато видите ярко червена храна или козметичен продукт, се сещайте за кохинил и за насекомите, от които е проиведено това багрило.
Кохинил, кармин, Е120 са три различни наименования за едно и също нещо. Цветът на кармина зависи от киселинността на веществото, съответно от съотношението на сместа на чистото вещество кохинил и алуминиевите или калциеви соли, с които е смесено. При по-висока киселинност (pH=3) карминът е с оранжев оттенък, при pH=5,5 цветът е червен, а пурпурен кармин се получава при алкална среда и pH=7.
Кохинилът или карминът е сравнително скъпо багрило. Каква е причината? За добиването на грам сухо вещество са необходими голямо количество насекоми, които трябва да се съберат и да се извлече от тях веществото. Това е бавен и трудоемък процес. По тази причина и цената на кармина не е ниска.
Безопасен ли е карминът?
Както вече стана ясно, по своята същност карминът, известен още като Е120, е натурален продукт, тъй като се извлича от насекоми. При извличането му не се прилагат сложни химични процеси. Въпреки това, не липсват потенциални рисков за някои групи хора, които консумират или използват продукти, в които се съдържа багрилото.
Едно от основните притеснения е свързано с алергичните реакции, които карминът може да предизвика. Известно е, че известен процент от хората са алергични към някои насекоми като например пчели, стършели и хлебарки.
При консумация на храни или при контакт с козметични продукти, съдържащи Е120, някои хора могат да получат кожни обриви, сърбеж или други проблеми от алергично естество. Това е особено често при козметични продукти като червила, които влизат в пряк контакт с кожата.
Макар карминът да е одобрен за употреба в повечето държави, той е забранен в нкои страни като например Япония и Саудитска Арабия. Тази мярка е предприета като предпазна, поради липсата на дългосрочни изследвания за влиянието му върху човешкото здраве.